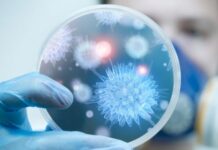
В Оше зарегистрированы случаи гонконгского гриппа

Садыр Жапаров принял верительные грамоты от послов девяти стран и провел две встречи
Сегодня, 5 декабря, Садыр Жапаров принял верительные грамоты от чрезвычайных и полномочных послов ряда иностранных государств, аккредитованных в стране. Об этом сообщает служба информационной...
На заведующую ЦСМ в Оше возбудили уголовное дело за незаконные сборы денег с пациентов
В Центре семейной медицины №4 Оша выявили систематические незаконные сборы денег с пациентов. Об этом сообщает пресс-служба ГКНБ КР. По данным ведомства, заведующая ЦСМ...
Зимний прием в вузы. ОРТ сдали 902 человека
Общереспубликанское тестирование абитуриентов для зимнего приема в вузы сдали 902 человека. Об этом сообщили в Центре оценки в образовании и методов обучения.
По его данным, в Бишкеке тест сдали 637 абитуриентов, в Оше — 229. Результаты ОРТ будут готовы после...
Штормовое предупреждение. В Кыргызстане 9-12 декабря ожидается резкое изменение погоды
В Кыргызстане 9-12 декабря ожидается резкое изменение погоды, сообщает МЧС КР.
Так, на большей части территории страны временами снег, местами осадки сильные. Налипание мокрого снега...
Убийство двухлетнего ребенка в «Кок-Жаре». Мать признали психически нездоровой
Дело об убийстве двухлетнего ребенка в новостройке «Кок-Жар» передали в Аламединский районный суд. Об этом сообщили в ГУВД Чуйской области.
Напомним, 22-летняя кыргызстанка и ее сожитель, гражданин Египта, обвиняются в убийстве...
В Кыргызстане до 1 июля продлевается работа по патентной системе в торговой сфере
В Кыргызстане до июля продлевается работа по патентной системе в торговой сфере. Об этом на встрече с торговцами рынка «Дордой» сообщил президент Кыргызстана Садыр...
Президент Садыр Жапаров прибыл на рынок «Дордой»
Президент Кыргызстана Садыр Жапаров прибыл на рынок «Дордой». Об этом агентству сообщил пресс-секретарь президента Аскат Алагозов.По его данным, на месте глава государства встретится с...
ГКНБ: В Джалал-Абаде за покровительство секс-притонов задержаны милиционеры
За покровительство притонов задержаны сотрудники милиции, сообщает пресс-служба Госкомитета нацбезопасности (ГКНБ) КР.
ГКНБ КР совместно с отделом службы внутренней безопасности УВД Джалал-Абадской области в рамках...
В Оше зарегистрированы случаи гонконгского гриппа
В Оше выявлен грипп A H3N2 (гонконгский грипп), сообщает Департамент профилактики заболеваний и госсанэпиднадзора.
По данным ведомства, по результатам лабораторных исследований анализов от больных, обратившиеся...
На рынок «Дордой» планирует приехать президент Садыр Жапаров. Уже прибыл мэр
Сегодня, 5 декабря, на рынке "Дордой" планировалось собрание предпринимателей. Но вскоре выяснилось, что ожидается приезд президента. По информации администрации рынка, к обеду планируется приезд...